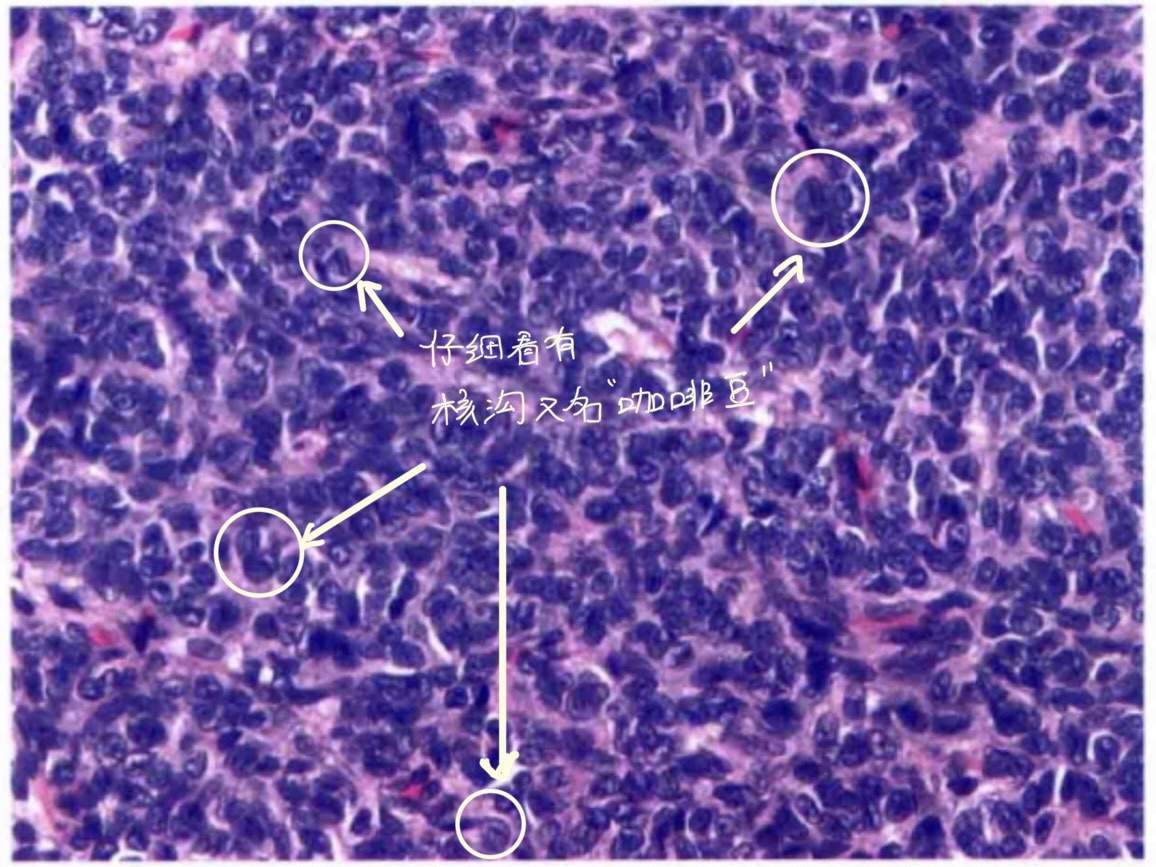
img

初学者笔记:卵巢的性索-间质肿瘤
推荐性索-间质肿瘤给我的第一个想法是,这个名字到底是个什么鬼?带着这个疑问我翻了一下WHO,看到了它一堆鬼画符一样的肿瘤名称,我迷茫了,于是开始各大平台找视频,但是,没找着。对一个有阅读障碍的人来说,自己看书,真的是走投无路的办法……
为了这篇文章,我翻了4本书,缠着我老师问了好多幼稚的问题,之后,我觉得用下面这句话开篇最合适不过。
顾名思义,性索-间质肿瘤,包括了性索和间质。在开篇之前,咱们就先来说说性索和间质。
性索与间质
说到“性索”就不得不说一下它的由来,许多胚胎学家认为体腔和中肾上皮参与了性索的形成,而性索是颗粒细胞(卵巢的)和Sertol细胞(睾丸的)的前体,虽然原始Sertoli细胞形成了细长的索状结构,但是在卵巢中却无类似的索状结构,所以,很多人认为这个术语不够准确,尽管如此,至今却没有找到更好的术语代替,所以沿用至今。
简言之,性索细胞在卵巢中叫卵泡细胞,而颗粒细胞其实就是图片中所描绘的“壁层”卵泡细胞,如图:


正如上图描绘的那样,卵巢的间质细胞就是外面的那层细胞,它还有个大名鼎鼎的名字—卵泡膜细胞。
在睾丸中叫Sertoli细胞(支持细胞)如图:




正如上图所描绘的那样,睾丸的间质细胞的另外一个大名鼎鼎的名字就是—Leydig细胞。
现在是不是清晰了呢?所谓的性索-间质细胞是不是也没有那么复杂呢?但是,我们不能忽略的是,卵巢和睾丸的间质不仅仅有卵泡膜细胞和Leydig细胞,还有纤维奥,所以纤维瘤在性索-间质细胞肿瘤中也是占有不容忽视的分量喔。
来自性索的:粒层细胞瘤
它分为两种类型:
1)成年型粒层细胞瘤

它有两个关键词:咖啡豆样的核和Call-Exner小体,看图:

粒层细胞瘤的另一个特点就是细胞核大小比较一致(和生殖细胞肿瘤比起来胞核比较大且染色也没有那么细腻);肿瘤内间质成分比较少(这一项是对比Sertoli-Leydig细胞瘤,后者肿瘤内有大量的间质成分);还有一个必须要鉴别的是卵泡膜细胞瘤(网状纤维染色)。

免疫组化表达性索间质:inhibit Calretinin。

2)幼年型粒层细胞瘤

相对比成年型,幼年型的关键词是:无核沟,罕见Call-Exner小体,平均发病年龄15岁,核分裂象多见预后比成年型好太多。如图:

来自间质的:卵泡膜-纤维瘤组肿瘤
卵泡膜-纤维瘤组肿瘤在可以区分来源时是一组疾病,在分不清楚来源(来源于纤维or来源于卵泡膜?)的时候也可以是一个疾病(可以直接用卵泡膜-纤维瘤组肿瘤来发报告)。
首先是卵泡膜细胞瘤

它的关键词:单个/小簇肿瘤细胞被网状纤维包绕(主要与粒层细胞瘤鉴别),以及,含有数量不等的黄素化细胞。如图:


再来是卵巢相关的纤维组织肿瘤
分为三个部分:
1)纤维瘤

经典的卵巢纤维瘤是梭形的,编织状的,如图:

但是,有些特殊类型却很难与卵泡膜细胞瘤区分,这种情况下,可以直接诊断为:卵泡膜-纤维组织肿瘤。如图:

2)富于细胞纤维瘤
在纤维瘤的基础上,核分裂大于等于4/10HPF,如图:

3)纤维肉瘤
在纤维瘤的基础上,多了胞核中-重度异形性,以及,核分裂4-25/10HPF。
性索和间质都有的:Sertoli-Leydig细胞瘤
首先,它显著的临床特征是男性化,且需要分级:
1)高分化:含有明显的管状结构(Sertoli细胞)
2)中分化:多种生长方式和细胞类型组成连续的形态学谱系。
3)低分化:除了存在具有特征性的诊断成分外,其形态学类似纤维肉瘤。


其次,中低分化时可有异源性成分(例如:黏液腺体/类癌细胞横纹肌/灶状软骨等)和(或)网状成分


最后,它有个特殊类型:网状型Sertoli-Leydig细胞肿瘤,如图:

不规则分枝状,细长,狭窄,常呈裂隙样。
最后说几个间质来源的特殊类型
1)硬化性间质瘤
它的关键词是:假小叶结构,如图:

正如图片所见,无论是疏松区域还是致密区域都是由肿瘤细胞构成,只是密度不同。
2)印戒细胞样间质瘤
它的关键词是:印戒样细胞不表达粘液不表达脂质,如图:

电镜观察标明,这里的印戒样细胞可能是基质水肿造成,也可能是线粒体肿胀造成。需要与Krukenberg瘤(黏液染色阳性+硬化性间质)鉴别。
3)Leydig细胞瘤
Reinke结晶是诊断它的铁证,如图:

典型的组织学形态也可以诊断,如图:

当,即没有Reinke结晶,有没有典型的组织学形态时常常被诊断为:类固醇细胞肿瘤。
其实,这个诊断用到的前提是全部取材并且镜下全部为这种结构,才可以诊断,和诊断Sertoli细胞瘤是一个道理,所以,可想而知,它们有多么的不常用……
写在最后的总结
我老师说,在性索-间质肿瘤中,最常用到的诊断有3个,分别是:粒层细胞瘤,卵泡膜-纤维瘤组肿瘤以及Sertoli-Leydig细胞瘤。
写到这里,常见的性索-间质肿瘤今本上都覆盖到了,没讲到的大家可以翻翻书在补充一下。附上一张高总结的图片,希望能帮到大家。

最后,作为一个初学者,我还有许多不足,希望大家多多包容,也欢迎大家批评指正,再次感谢大家对我的关注与认可!
















































